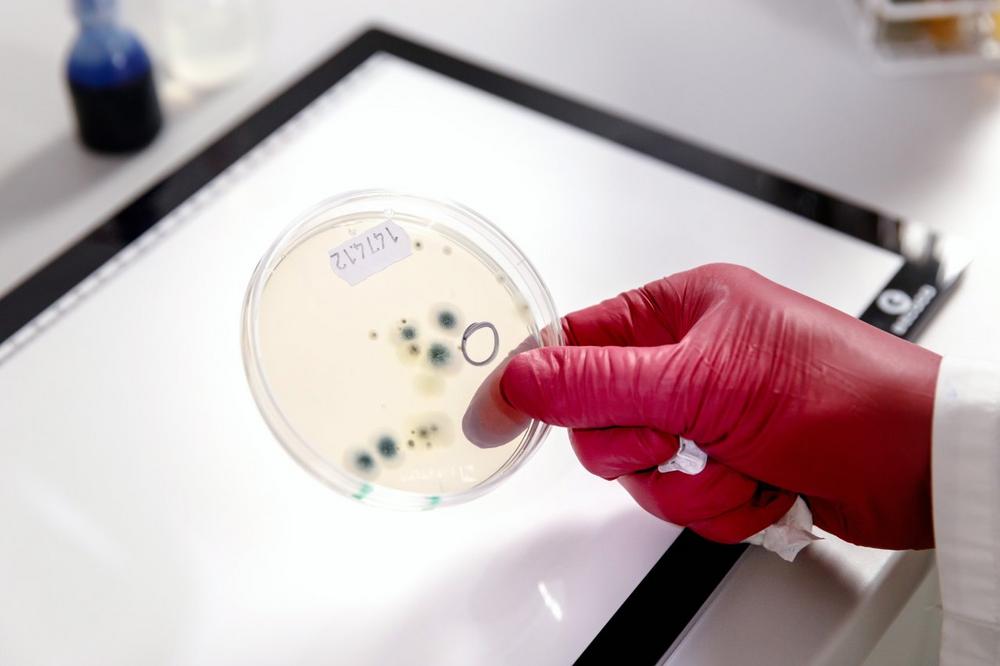

Auf diese Idee war Walter Schmidt nicht gekommen. Den Hausbesitzer plagten nämlich über Jahre hinweg Beschwerden an Augen, Nase und Atmung, die er auf Heuschnupfen zurückführte. Nachdem sich typische Symptome auch außerhalb der Pollenflugzeit bei ihm äußerten, wurde er stutzig. Untersuchungen ergaben, dass der Auslöser seiner Allergie nicht Blütenpollen, sondern Schimmelpilz war. Dieser hatte sich im Keller seiner 1992 gebauten Doppelhaushälfte eingenistet. Über die offene Treppe zwischen Keller- und Erdgeschoss konnten sich die Schimmelporen ungehindert im ganzen Haus verbreiten.
Zwar stellten er und seine Ehefrau Carla Feuchtigkeitsprobleme im Keller fest. Schimmelpilz und einen Zusammenhang mit den gesundheitlichen Beschwerden des Hausbesitzers erahnten sie aber nicht. „An Schimmelpilz als Ursache für meine Allergie hatte doch keiner gedacht“, so Walter Schmidt.
Klarer Zusammenhang zwischen Schimmelpilzbefall und allergischen Reaktionen
Thomas Molitor ist stellvertretender Technischer Leiter bei ISOTEC, einer Unternehmensgruppe, die den Feuchte- und Schimmelschaden bei den Schmidts beseitigte. Er stellt dazu fest: „Wir entdecken häufig, dass sich Schimmelpilz hinter Wandverschalungen oder auch hinter der Tapete verbirgt.“ Das eindeutige Ergebnis lieferte schließlich ein Baubiologe, den ISOTEC hinzugezogen hatte. Dieser führte Kernbohrungen durch und stellte in der Waschküche und im Vorraum des Kellers einen Befall mit dem gesundheitsschädigenden und allergieauslösenden Schimmel Stachybotrys fest, einzuordnen in Kategorie 3. Derartiger Schimmel ist sogar erheblich gesundheitsgefährdend und darf ausschließlich von Fachleuten entfernt werden.
Zu Beginn der Sanierungsmaßnahme wurde zunächst der Schimmelpilzbefall beseitigt. Das ISOTEC-Fachunternehmen schottete dafür die betroffenen Kellerräume staub- und luftdicht ab, erzeugte einen Raumluftunterdruck und entfernte den Schimmelbefall. Anschließend mussten die befallenen Bereiche gründlich gereinigt und die kontaminierten Flächen mit Isopropyl-Alkohol desinfiziert werden. Erst danach erfolgte die weitere Sanierung des eigentlichen Feuchteschadens sowie die Beseitigung der Ursachen.
Eine sogenannte „Freimessung“ wurde nach der Sanierung als Erfolgskontrolle durchgeführt. Sie ergab, dass das Haus von Familie Schmidt endlich frei von Schimmelsporen war. „Jetzt haben wir die Sicherheit, dass der giftige Pilz beseitigt ist. Und auch der muffige Geruch ist nach der Sanierung vollständig weg“, sagt Walter Schmidt erleichtert. Nicht nur das: Die gesundheitlichen Beschwerden, die der Hausherr über Jahre auf Heuschnupfen zurückführte, haben sich erledigt.
Weitere Informationen unter www.isotec.de
ISOTEC GmbH
Köttgen-Allee 1
51465 Bergisch Gladbach
Telefon: +49 (0)2202 / 95 74 261
http://www.isotec.de
Telefon: +49 (2207) 8476106
E-Mail: bahne@isotec.de
![]()